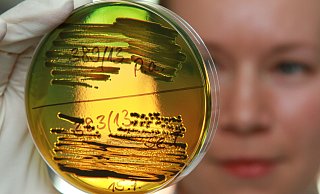
Eine Laborantin im Robert Koch Institut vergleicht eine biochemische Testung zur Unterscheidung von verschiedenen Arten von Durchfallerregern. - Matthias Bein/picture alliance/ZB

Wirtschaft im Kreis Herford
Die Wirtschaft im Kreis Herford ist geprägt durch eine starke mittelständische Struktur mit vielen namenhaften und international bekannten Unternehmen. Etwa das Modeunternehmen Bugatti und der Küchenmöbelhersteller Nolte Küchen gehören zu den größten Arbeitgebern im Kreis Herford. Alle Informationen und Berichte zu Wirtschaftsthemen im Kreis Herford finden Sie auf dieser Themenseite.

Brax in Herford: Das sind die Modetrends für den Sommer 2026
Brax zeigt Trends für den nächsten Sommer, unter anderem inspiriert von Julian Nagelsmann. Frauen können sich auf die Rückkehr der Mom-Jeans freuen.
Sommer im Kreis Herford: Vorsicht vor immer mehr Magen-Darm-Infektionen
Die Erkrankung ist zwar in der Regel harmlos und verschwindet häufig schon nach kurzer Zeit wieder. Aber sie ist hochansteckend und es kann zu Risiken kommen.

Das Café am Markt in Bünde hat einen neuen Betreiber
Die Wiedereröffnung könnte noch im Juli erfolgen. Der neue Betreiber möchte Bewährtes übernehmen. Seine Mitarbeiterin ist eine „alte Bekannte“ für viele Bünder.

Neuer Fashion-Partner von Arminia Bielefeld: Bugatti aus Herford stärkt eigene Marke
Traditionsunternehmen aus Herford setzt neues Zeichen im Fußball. Partnerschaft startet zur Saison 2025/26.

Diese Herforder Schulen werden in den Sommerferien erneuert und erweitert
Während Schüler ihre Sommerferien genießen, sind Handwerker in den Schulen im Einsatz. Nicht alle Arbeiten werden bis zum Ende der Ferien fertig.

Vom Retter zum Krisenfall: Möbelhersteller aus Herford ist jetzt selbst insolvent
Erst Ende 2024 kaufte das Unternehmen einen insolventen Konkurrenten aus Lübbecke auf. Nun steht der Möbelkonzern selbst vor der Pleite. Wie es nun weitergeht.

Wirtschaftstrend im Kreis Herford: Die Bau- und Immobiliengeschäfte ziehen an
Die Sparkasse Herford gibt einen Ausblick auf das laufende Jahr und gibt ihre Zahlen für 2024 bekannt. Der Gewinn wird an fünf Adressaten überwiesen.

Sparkasse Herford hat zwei neue Vorstände
Die Nachfolge für Horst Prüßmeier ist geklärt. Die neuen Manager kommen aus Bayern und aus dem Ruhrgebiet. Gesucht wird nun noch eine weitere Top-Position.

Mutterkonzern insolvent: Steht der Hammer Einrichtungsmarkt in Herford vor dem Aus?
Schon länger strauchelte der Konzern, unter dessen Regie, die Hammer-Märkte laufen. Jetzt wurde Insolvenz in Eigenregie beantragt. Mit Folgen für Herford.

Herforder Hoeker-Fest im Preis-Check: Das kosten Bier, Bratwurst & Co. in diesem Jahr
Das beliebte Herforder Stadtfest wird auch in diesem Jahr wieder Hunderttausende in die Innenstadt locken. Doch wie haben sich die Preise entwickelt?

Das hat der neue Supermarkt in Spenges Zentrum zu bieten
Jasmin und Mehdi Fakhro haben am Blücherplatz den „Jasmina-Markt“ eröffnet. Was sie dort anbieten und um was sie ihr Sortiment noch erweitern wollen.

„Laut und aggressiv“: Glasfaser-Werber bedrängen 90-Jährige in Rödinghausen
Christian Otte (64) und seine Mutter (90) haben eine unschöne Begegnung gehabt. Wie äußert sich die Deutsche Glasfaser Unternehmensgruppe dazu?

Bekannter Bünder Gastronom startet neu durch: So sieht sein Konzept aus
Georgios Rizos heißt seine Gäste ab diesem Samstag an der Bahnhofstraße willkommen. Was ihnen geboten wird und was er in Zukunft noch vorhat.

Nach nur sieben Monaten: Dieses Geschäft in der Engeraner Innenstadt schließt
Die Betreiber wollten qualitativ hochwertige Möbel verkaufen, ziehen nun aber die Notbremse. Einen neuen Mieter soll es schon geben.

So sportlich ist Herford: Rekordteilnahme und 15-Minuten-Sieger beim AOK-Firmenlauf
Knapp 3.000 Teilnehmer rennen oder walken rund um den Wall der Werrestadt. Danach ist Party angesagt. Die Veranstalter sind mehr als zufrieden.

Früherer TV-Koch aus Herford hat Ärger vor Gericht
Vor dem Amtsgericht in Bielefeld geht es am Montagmorgen um sein im Frühjahr 2024 geschlossenes Restaurant „Mirror“ an der Ahmser Straße. Doch er hat Glück.

Verkehr in Löhne: Einwohner klagen über hohe Belastung und fordern Änderungen
Große Umfrage: Drei Wochen lang möchten wir von unseren Leserinnen und Lesern wissen, was sie an ihrer Heimat lieben. Und was noch verbesserungswürdig ist.

„Mexim’s“-Restaurants in Bünde und Bielefeld insolvent
In Bünde läuft der Betrieb vorerst weiter. In Bielefeld hat das Lokal bereits geschlossen. Insolvenzverwalter Frank Schorisch klingt verhalten zuversichtlich.

Herforder Büroartikelhersteller HAN trotz Insolvenz optimistisch
Vor Kurzem hat der traditionsreiche Büroartikelhersteller HAN in Herford Insolvenz angemeldet. Nun äußert sich das Unternehmen und verbreitet Optimismus.

40 Meter in die Höhe: Löhner Logistiker plant große Erweiterung auf wenig Fläche
Die Firma Kemena möchte erweitern. Die Ideen zeugen von nachhaltigen Gedanken, nehmen aber auch ganz neue Dimensionen an.

Herforder Olympia-Sieger Brinkmann feiert 75. Geburtstag mit Pferden & Mode
Wolfgang Brinkmann wird 75. Der Herforder Unternehmer widmet sich mit großer Begeisterung der Pferdezucht.

Clubs sind out: Die Herforder Go-Parc-Insolvenz kommt wenig überraschend
Herford Kultclub hat schon einmal bewiesen: Eine Krise muss nicht unbedingt das Ende bedeuten. Doch die Herausforderungen sind diesmal weitaus schwieriger.

Schwerer Schlag für die OWL-Partyszene: Der Go Parc in Herford meldet Insolvenz an
Seit Wochen haben sich die Hinweise gemehrt, dass der bekannte Club in einer Krise steckt. Nun herrscht traurige Gewissheit.

Herforder Büroartikelhersteller beantragt Insolvenz
Die Herforder Firma HAN stellt Büroartikel wie Ablagesysteme und Papierkörbe in modernem Design her. Nun beantragt sie die Insolvenz. Das ist die Lage.

Blick hinter die Kulissen: Millionen-Investitionen stärken Miele-Werk in Bünde
Nach einer turbulenten Phase geht es beim Haushaltsgerätehersteller wieder aufwärts. Das hat auch etwas mit der Leistungsfähigkeit des Imperial-Werks zu tun.